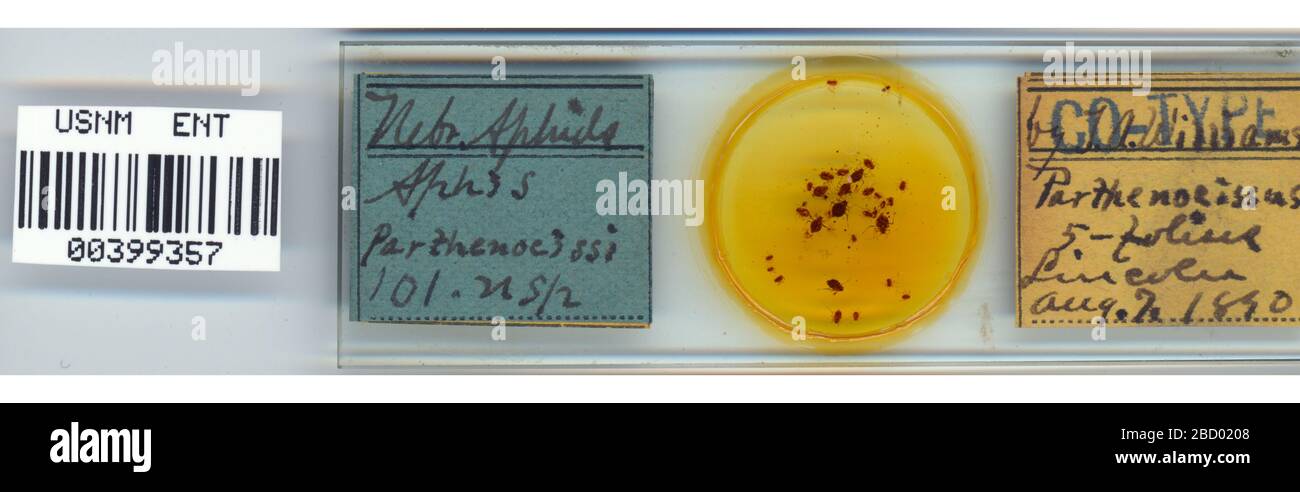
APHIS parthenocissi. 7 octobre 20151 Aphis parthenocissi Banque D'Images

Maladies des plantes Photos Stock & Des Images
(46,689)Filtres rapides :
Maladies des plantes Photos Stock & Des Images

RMJ8BA7C–'Flora Homoeopathica' est un travail lié à la médecine homéopathique et à son utilisation dans le traitement des maladies des plantes. Il explore la relation entre les plantes et les pratiques de guérison alternatives.

RMHA0DDM–Boge Moore, un expert de l'USDA, travaille sur les sciences agricoles et la recherche environnementale pour améliorer la durabilité agricole, en se concentrant sur les maladies des plantes et la lutte antiparasitaire.

RF2JAG219–les jeunes plants de chou sont endommagés par des insectes nuisibles, des chenilles et des vers de chou, des tiques et des maladies végétales

RMTRTFJP–Face supérieure de Dock à larges feuilles Rumex obtusifolius leaf touchés par la rouille Puccinia phragmitis Dock

RF2PY7DAD–Les jeunes raisins verts pendent sur les branches de la vigne. Les raisins non mûrs comme culture future. Maladies des plantes. Feuilles de raisin vert. Serbie, Voïvodine, Sremska Mitrovica. Vinification en Serbie

RF2YG5BD7–Tomates mûres et non mûres dans la serre, potager en ruine, tomates n'ont pas réussi à récolter, tomates assèchent, maladies des tomates

RF2GF1TXF–Dommages bruns et jaunes par l'anthracnose sur la feuille verte de l'arbre de la plante de café de Robusta, maladies végétales qui endommagent l'agriculture

RFRX1F8R–En succulentes Haworthia pot de fleurs, mini outils de jardin et les remèdes homéopathiques pour l'usine. Autre traitement naturel des maladies des plantes.

RF3BH89NH–Gros plan des feuilles de cycas revoluta montrant une infection fongique causant des taches jaunes, soulignant l'impact des maladies des plantes sur la santé du feuillage

RMKTKK22–Berberis thunbergii, communément appelé épine-vinette japonaise, est une espèce végétale souvent affectée par des ravageurs tels que l'acarien tétranychus. L'espèce est utilisée dans l'aménagement paysager, bien qu'elle soit confrontée à des défis liés aux maladies des plantes et aux ravageurs.

RMHA728X–Le Pennsylvania Plum Pox Eradication Project a reçu le 62e prix d'honneur, reconnaissant les efforts pour lutter contre les maladies des plantes et préserver la biodiversité agricole aux États-Unis sous la direction de l'USDA.

RF2WR5CB8–Feuille de groseille infectée par des ravageurs - puceron gallique Capitophorus ribis, Aphidoidea. Les pucerons absorbent la sève de la plante, les feuilles se déforment, rouges

RF2X33XBF–Ravageurs de jardin infectant et endommageant les feuilles de chou-fleur indiquant des maladies communes des plantes. Maladies des plantes

RF2HH9APA–La racine de soja infectée par une maladie qui provoque le flétrissent de toute la plante et entraîne des pertes.

RF2PY7DA9–Les jeunes raisins verts pendent sur les branches de la vigne. Les raisins non mûrs comme culture future. Maladies des plantes. Feuilles de raisin vert. Serbie, Voïvodine, Sremska Mitrovica. Vinification en Serbie

RF2YG5B7M–Tomate cerise mûre dans une plante de tomate morte, jardin potager en ruine, échec de la récolte, feuilles et plantes de tomate assèchent, maladies des plantes de tomate

RMR1XNWX–Close-up de pivoine les feuilles des plantes infectées par la pourriture grise ou botrytis blight brûlure

RM2BF2326–Sharpshooter. Cet objet fait partie de la collection éducation et sensibilisation, dont certaines sont dans le centre d'éducation scientifique Q?rius et sont disponibles pour voir.114 Jan 2020

RMF3X201–Pied pourriture sur jeune plant de tomate mycélium blanc ceinture la tige et les feuilles se flétrissent

RF2GEF92T–Dommages bruns et jaunes par l'anthracnose sur la feuille verte de l'arbre de la plante de café de Robusta, maladies végétales qui endommagent l'agriculture

RFRX1F8P–En succulentes Haworthia pot de fleurs, mini outils de jardin et les remèdes homéopathiques pour l'usine. Autre traitement naturel des maladies des plantes. Vue d'en haut. Fl

RF3BH89MR–Gros plan d'une feuille de cycas revoluta affectée par une infection fongique, présentant de petites taches orange, soulignant l'impact des maladies des plantes sur la santé du feuillage

RFMTJRNA–Haut de l'ananas et pourriture des racines (Phytophtora cinnamomi et P. nicotianae var. parasitica)

RMKTMJTK–La gale d'avocat est une maladie fongique qui affecte les avocats, causant des lésions de surface sur le fruit. Cette image de 2017 montre l'impact de la maladie sur les cultures d'avocats.

RMHA844P–Le Programme d'action des services internationaux de l'APHIS vise à protéger la santé et la sécurité des écosystèmes des parcs nationaux en gérant les maladies animales et végétales. Le programme met l'accent sur la prévention, la détection et l'éradication des espèces nuisibles et des maladies.

RF2WR5CAB–Feuille de groseille infectée par des ravageurs - puceron gallique Capitophorus ribis, Aphidoidea. Les pucerons absorbent la sève de la plante, les feuilles se déforment, rouges

RF2XJNAJP–plante d'écorce, le peuplier est coloré en blanc en de nombreux points de son écorce, dans la forêt vous pouvez facilement distinguer d'autres plantes.

RF2M1796D–Des échantillons des tiges de l'usine de céréales sont touchés par le Pyrenophora tritici-repentis champignon

RF2PY7DAC–Les jeunes raisins verts pendent sur les branches de la vigne. Les raisins non mûrs comme culture future. Maladies des plantes. Feuilles de raisin vert. Serbie, Voïvodine, Sremska Mitrovica. Vinification en Serbie

RF2HHXY0H–Greffe printanière de plantes de maison dans le sol fertilisé. Les mains de femme avec pelle de jardin sont transplantées dans un nouveau pot de fleur tropical plante spathiphyl

RF3D1DREP–Souche d'arbre couverte de champignon de miel. Le champignon du miel est le nom de plusieurs espèces d'Armillaria qui attaque les racines des plantes vivaces ligneuses (A. mellea)

RF2X33XDN–Main humaine examinant des feuilles de pommier infestées de pucerons nécessitant une pulvérisation et un traitement de lutte antiparasitaire. Maladies des plantes.

RF2RPJA02–Dommages marron et jaune par l'anthracnose sur la feuille verte de l'arbre de la plante de café de Robusta, maladies végétales qui endommagent l'agriculture

RFC2DDMR–Les plants de tomates à la tomate (nom scientifique ' Phytophthora infestans") d'être brûlé pour arrêter la propagation de la maladie.

RM2FGX9TX–Fuzhou. 31 décembre 2020. Photo prise le 31 décembre 2020 montre des caméras surveillant les maladies et les ravageurs des plantes dans une ferme de thé intelligent avec assistance de 5G à Fu'an City, dans la province du Fujian, au sud-est de la Chine. Crédit: Lin Chao/Xinhua/Alay Live News

RF3BH89TN–Gros plan d'une feuille de cycas revoluta montrant une infection fongique causant des taches jaunes, soulignant l'impact des maladies des plantes sur la santé du feuillage et la valeur ornementale

RM2JW3HWB–Des galettes sur les feuilles de bois de chien (Cornus sanguinea) causées par les larves du mousde de rivet de bois de chien Craneiobia corni, Hampshire, Angleterre, Royaume-Uni

RMKF0WK8–Johanna Westerdijk était une phytopathologiste néerlandaise qui a apporté des contributions significatives dans le domaine de la mycologie. Elle est connue pour ses travaux pionniers sur les maladies fongiques affectant les plantes et ses études sur la relation entre les champignons et la santé des plantes. Westerdijk a été la première femme à occuper un poste de professeur dans une université néerlandaise et a joué un rôle crucial dans l'avancement de la pathologie végétale aux pays-Bas.

RMH9Y7PE–Le Service d’inspection de la santé animale et végétale (APHIS) de l’USDA travaille à protéger l’agriculture américaine en surveillant la santé animale et les maladies végétales. En utilisant des aéronefs et d'autres outils, l'APHIS assure la détection précoce et le confinement des menaces agricoles potentielles, protégeant les cultures et le bétail à l'échelle nationale.

RF2WY9FDW–Feuille de groseille infectée par des ravageurs - puceron gallique Capitophorus ribis, Aphidoidea. Les pucerons absorbent la sève de la plante, les feuilles se déforment, rouges

RF2XJNAWH–plante d'écorce, le peuplier est coloré en blanc en de nombreux points de son écorce, dans la forêt vous pouvez facilement distinguer d'autres plantes.

RF2KECW9B–Nectria cinnabarina, également connu sous le nom de tache de corail, est un pathogène de plante qui provoque des chancres sur les arbres à feuilles larges.

RF2PY7DA8–Les jeunes raisins verts pendent sur les branches de la vigne. Les raisins non mûrs comme culture future. Maladies des plantes. Feuilles de raisin vert. Serbie, Voïvodine, Sremska Mitrovica. Vinification en Serbie

RF2HHXY3Y–Greffe printanière de plantes de maison dans le sol fertilisé. Les mains de femme avec pelle de jardin sont transplantées dans un nouveau pot de fleur tropical plante spathiphyl

RFM5MWJM–L'agriculture intelligente , internet des objets (iot) concept de la technologie. Appareil de traitement de l'image de l'intelligence artificielle identifier les maladies des plantes en strawbe

RF2SM8Y32–Plante intérieure de Calathea avec des feuilles fanées – signes de maladie et besoins de soins

RM2AKWC24–Yaoundé, Cameroun. 6e déc, 2019. Les gens utilise Agrix Tech, une application mobile qui détecte les maladies des plantes au stade primaire par l'analyse de photos de la cultures malades, au terrain dans Dibombari, le Cameroun, le 6 décembre 2019. Pour aller avec la fonction 'Cameroun : développer les start-ups du mobile app pour aider les agriculteurs locaux en matière de crédit : Jean Pierre Kepseu/Xinhua/Alamy Live News

RFMWR1GC–MOISISSURE POUDREUSE SUR LE CUCURBIT.LES PLANTES INFECTÉES PRÉSENTENT DES TACHES BLANCHES DE POUDRE SUR LES FEUILLES ET LA TIGE.

RM2JW3HW3–Des galettes sur les feuilles de bois de chien (Cornus sanguinea) causées par les larves du mousde de rivet de bois de chien Craneiobia corni, Hampshire, Angleterre, Royaume-Uni

RF2JRYTY5–Les maladies infectieuses des plantes sont causées par des agents vivants ou des agents pathogènes. Voici quelques feuilles vertes infectées dans le foyer.

RMKYMK93–Portrait de Frances Jean MacInnes, pionnière en pathologie végétale, présenté dans le cadre de l’histoire des maladies des plantes et des études sur les champignons hivernaux au début du XXe siècle.

RF2JK7476–Chou insectes endommagés insectes ravageurs gros plan, laisse le chou dans le trou, mangé par les larves papillons et chenilles. Maladies des plantes

RF2G8C1HH–La feuille de pêche s'enroule sur les feuilles de cassis. Maladies des plantes communes. Feuilles puckées ou bourrées déformées par des pucerons jaune pâle. Homme tenant un rougeâtre ou

RF2HA81B4–Moule à sucette moule noir sur oreilles de blé, Cladosporium herbarum Alternaria alternata.Maladies des céréales, maladies de l'oreille.

RF2KG1K1F–La maladie fongique le mildiou poudreux sur une plante de rose. Plaque blanche sur les feuilles et les tiges. Sécher les feuilles gondolée. Maladies des plantes. Gros plan.

RF2CAR5D5–Moisissure poudreuse sur la feuille d'érable. Taches blanches de moisissure poudreuse sur l'érable. Champignons pathogènes, phytopathologie, maladies des plantes concept

RM2REM2A0–Gymnosporangium sabinae (Gymnosporangium sabinae), maladies des plantes, maladies des plantes

RMJ6P9BG–Le Senna alata, communément appelé buisson de teigne, est une plante tropicale originaire des Philippines. Ses fleurs jaunes sont utilisées en médecine traditionnelle pour traiter les infections fongiques et les maladies de la peau.

RFM5MWJN–L'agriculture intelligente , internet des objets (iot) concept de la technologie. Appareil de traitement de l'image de l'intelligence artificielle identifier les maladies des plantes en strawbe

RF2G6PN26–Dommages bruns et jaunes par l'anthracnose sur la feuille verte de l'arbre de la plante de café de Robusta, maladies végétales qui endommagent l'agriculture

RM2AKWC11–Yaoundé, Cameroun. 6e déc, 2019. Landry Doko co-fondateur de Agrix Tech, une application mobile qui détecte les maladies des plantes au stade primaire par l'analyse de photos de la cultures malades, est perceptible au niveau du terrain à Dibombari, le Cameroun, le 6 décembre 2019. Pour aller avec la fonction 'Cameroun : développer les start-ups du mobile app pour aider les agriculteurs locaux en matière de crédit : Jean Pierre Kepseu/Xinhua/Alamy Live News

RF2K5KTBH–Moule à feuilles de tomate. Cladosporium fulvum maladies des plantes sur les feuilles de tomate avec des taches jaune pâle. Dommages fongiques. Symptômes précoces.

RFF19HEC–Les symptômes de la tavelure (Venturia inaequalis) SUR LE CRABE POMMIER (également connu sous le nom de point noir)

RM2JW3HKY–Signes de dépérissement des cendres chez les cendre (Fraxinus excelsior), causés par Hymenoscyphus fraxineus, un champignon ascomycète, Royaume-Uni

RF2JRYTYG–Les maladies infectieuses des plantes sont causées par des agents vivants ou des agents pathogènes. Voici quelques feuilles vertes infectées dans le foyer.

RMHA85D8–Cette image capture un projet de recherche de l'USDA sur le biocontrôle des maladies des plantes de blé, mettant en évidence les efforts scientifiques pour protéger les cultures en utilisant des bactéries naturelles pour améliorer l'agriculture.